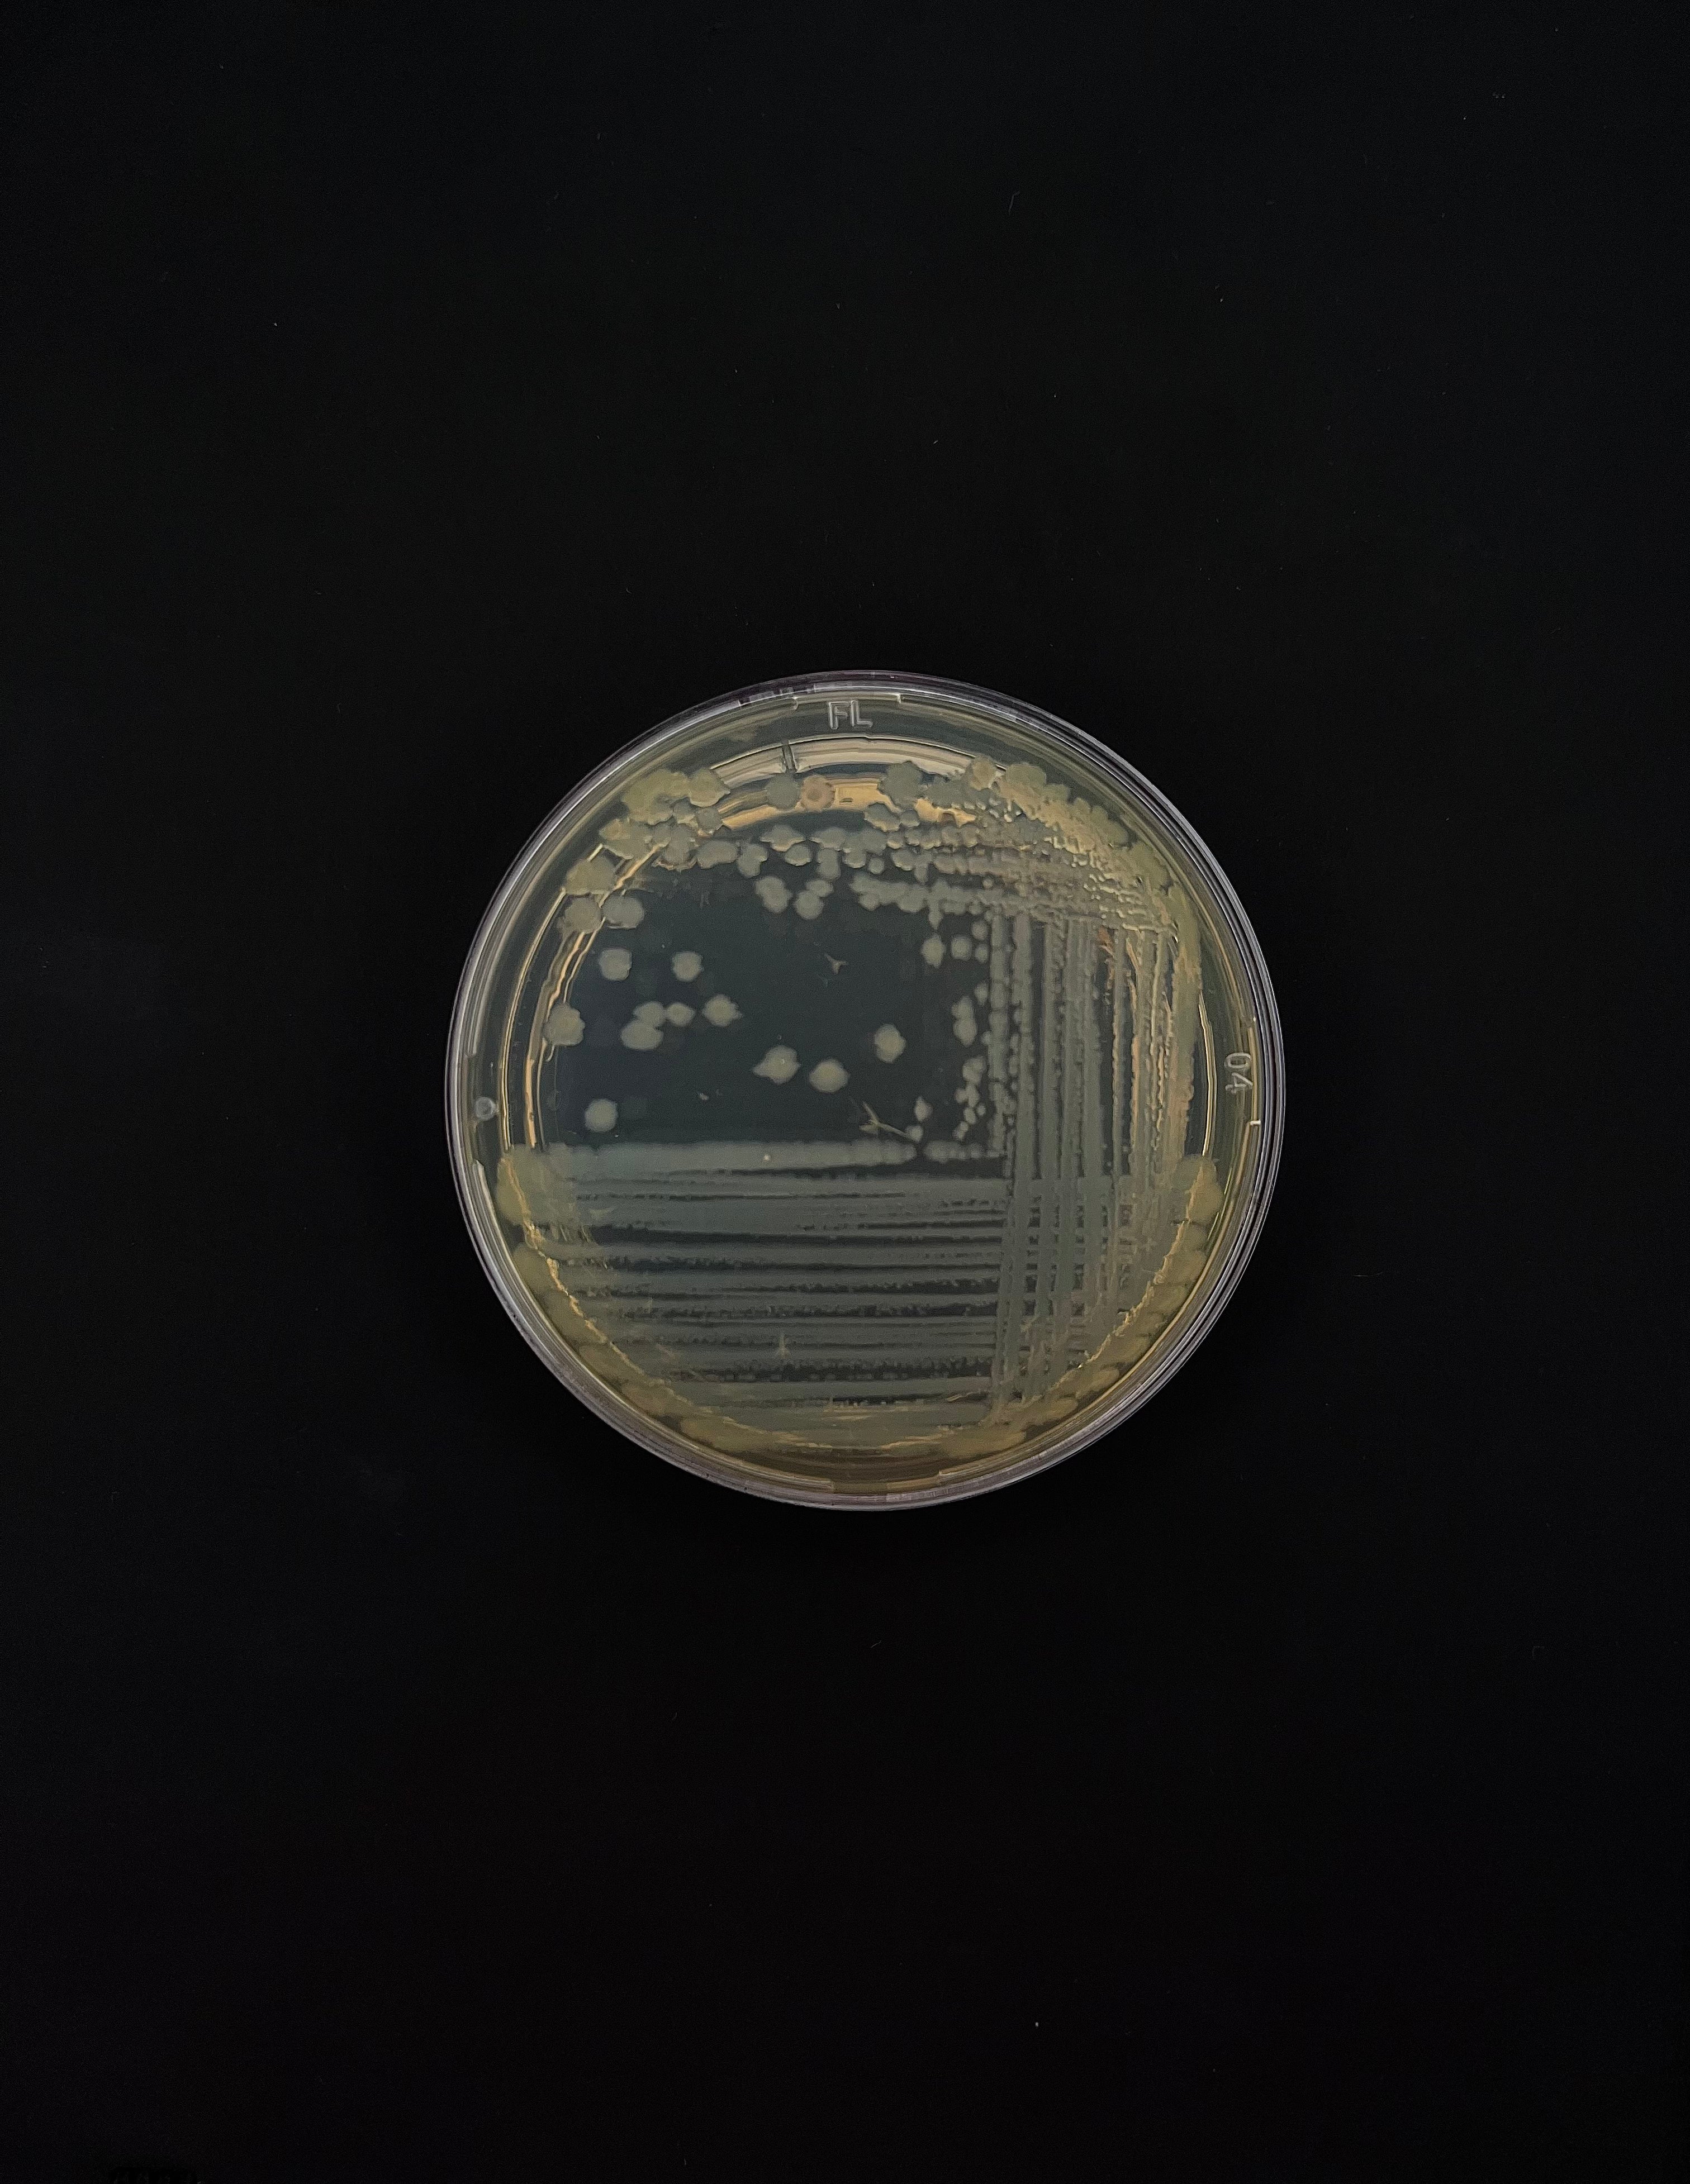
A (r)evolução brasileira da biotecnologia nos cosméticos

Por Eduardo de Angelis
Pura emoção: como a neurociência transforma os cosméticos em experiências de bem-estar
Por Eduardo de Angelis
Em Destaques, Sustentabilidade
O que são marcas com propósito e por que elas importam
A (r)evolução brasileira da biotecnologia nos cosméticos
Por Eduardo de Angelis
em
Pura emoção: como a neurociência transforma os cosméticos em experiências de bem-estar
Por Eduardo de Angelis
em
O que são marcas com propósito e por que elas importam
Por Eduardo de Angelis
em